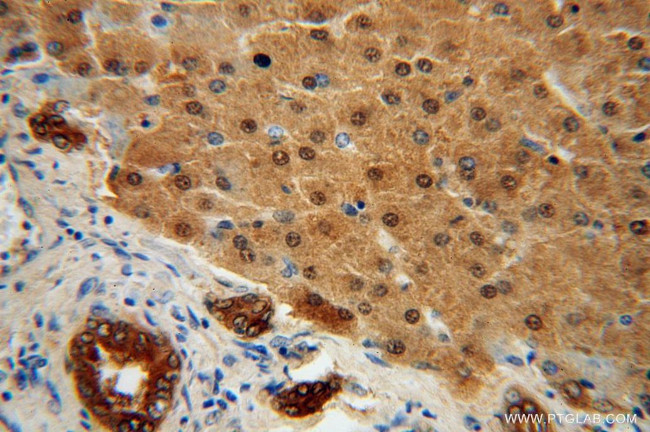
STARD10 Antibody in Immunohistochemistry (Paraffin) (IHC (P))

Search
Proteintech
STARD10 Polyclonal Antibody
{{$productOrderCtrl.translations['antibody.pdp.commerceCard.promotion.promotions']}}
{{$productOrderCtrl.translations['antibody.pdp.commerceCard.promotion.viewpromo']}}
{{$productOrderCtrl.translations['antibody.pdp.commerceCard.promotion.promocode']}}: {{promo.promoCode}} {{promo.promoTitle}} {{promo.promoDescription}}. {{$productOrderCtrl.translations['antibody.pdp.commerceCard.promotion.learnmore']}}
产品信息
17048-1-AP
种属反应
宿主/亚型
分类
类型
抗原
偶联物
形式
浓度
规格
纯化类型
保存液
内含物
保存条件
运输条件
产品详细信息
This antibody detected duplicate bands between 35-40 kDa in MCF7 and HepG2 cells. The similar expression pattern of STARD10 was also observed by other scientists, while the exact reason is not clear.
Immunogen sequence: MEKLAASTE PQGPRPVLGR ESVQVPDDQD FRSFRSECEA EVGWNLTYSR AGVSVWVQAV EMDRTLHKIK CRMECCDVPA ETLYDVLHDI EYRKKWDSNV IETFDIARLT VNADVGYYSW RCPKPLKNRD VITLRSWLPM GADYIIMNYS VKHPKYPPRK DLVRAVSIQT GYLIQSTGPK SCVITYLAQV DPKGSLPKWV VNKSSQFLAP KAMKKMYKAC LKYPEWKQKH LPHFKPWLHP EQSPLPSLAL SELSVQHADS LENIDESAVA ESREERMGGA GGEGSDDDTS LT (1-291 aa encoded by BC007919)
靶标信息
STARD10 gene ontology annotations related to this gene include bile acid secretion; positive regulation of peroxisome proliferator activated receptor signaling pathway.
仅用于科研。不用于诊断过程。未经明确授权不得转售。
篇参考文献 (0)
生物信息学
蛋白别名: Antigen NY-CO-28; CGI52; PCTP-L; PCTP-like protein; Serologically defined colon cancer antigen 28; StAR-related lipid transfer (START) domain containing 10; StAR-related lipid transfer protein 10; StARD10; START domain containing 10; START domain-containing protein 10; unnamed protein product
基因别名: CGI-52; NY-CO-28; PCTP2; SDCCAG28; STARD10
UniProt ID: (Human) Q9Y365
Entrez Gene ID: (Human) 10809